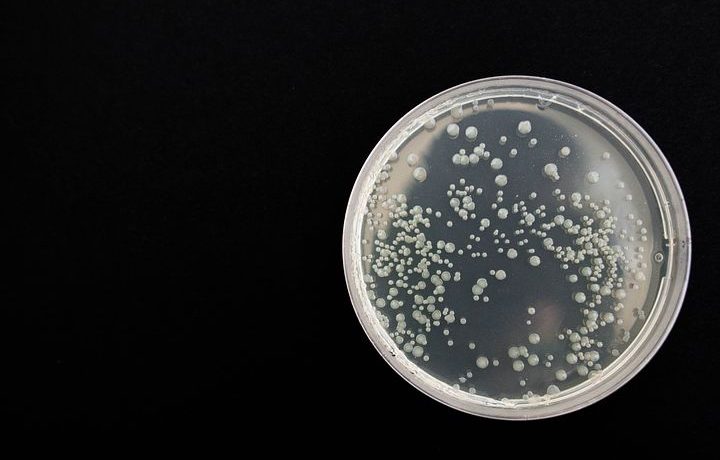
Microbiomul -important pentru prevenirea/tratarea cancerului Microbiomul

Noul aparat Transilvania Healing Centre
Fiind adepții dezvoltării continue în vederea evoluției în termeni de știință și tehnologie, menținem deschisă lista achizițiilor și ne asigurăm că deținem cea mai inovativă aparatură medicală. Așadar, ne bucurăm să vă putem prezenta astăzi cel mai nou aparat al clinicii. Folosindu-se de un spectru mai